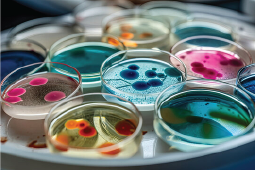

Capabilities
Go Beyond Standard Testing,
Make Confident Decisions
New
Section
Results Built for Environmental & Regulatory Confidence
Testing That Works for the Field
Testing That Works for the Field
BLS Testing
Environmental Chemistry - Custom Test Grouping - Metals - Microbiological
BLS Testing Options
Environmental Chemistry - Custom Test Grouping - Metals - Microbiological